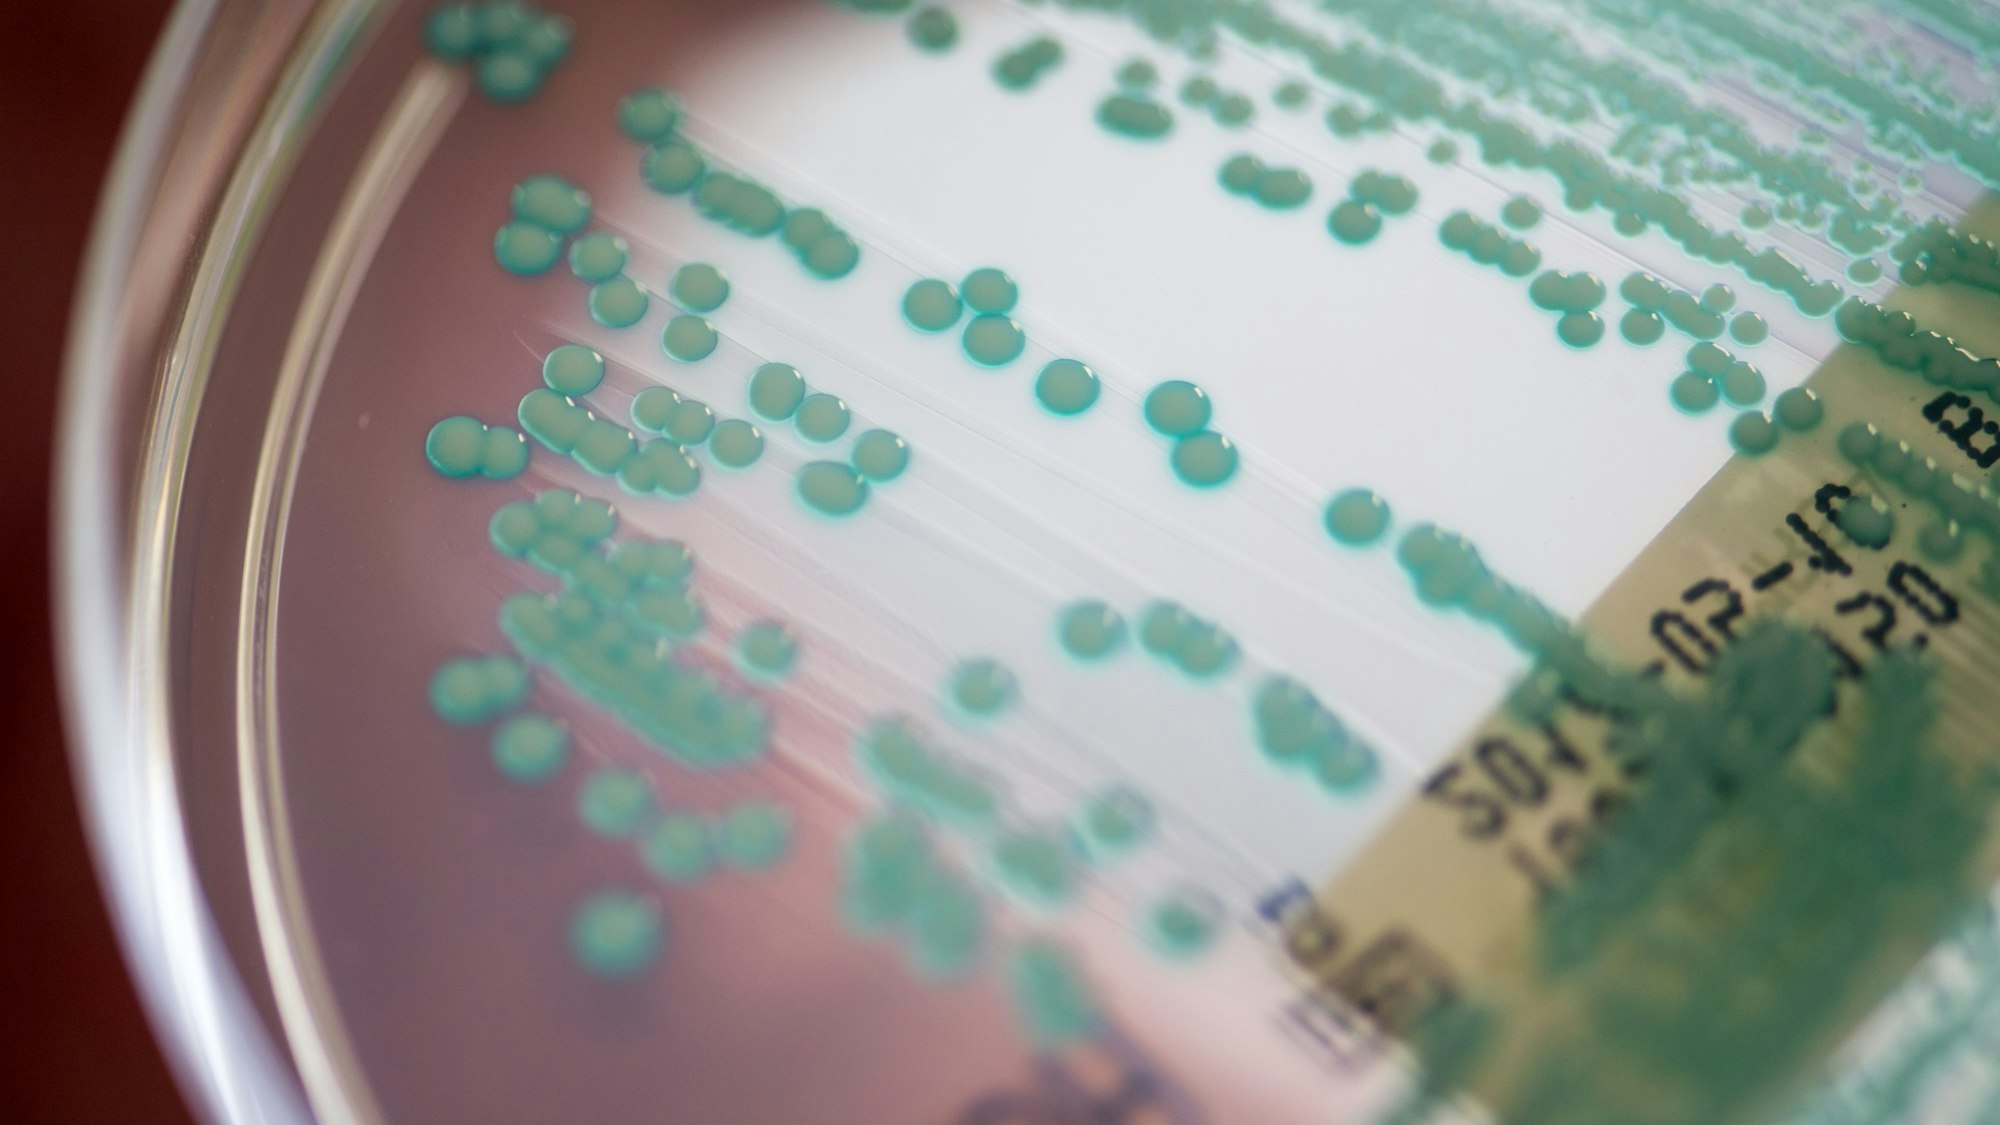
Eine Petrischale mit Methicillin-resistenten Staphylococcus aureus-Keimen

Der Kreis Euskirchen schließt sich im Kampf gegen multiresistente Krankenhauskeime einem erprobten Netzwerk an.
Multiresistente KeimeKreis Euskirchen nutzt Netzwerk im Kampf gegen gefährliche Erreger
Eine Petrischale mit MRSA-Keimen
Copyright: picture alliance/dpa
„Wenn jemand ins Krankenhaus kommt, dann soll er nicht krank werden, sondern gesund“, sagt Professor Niko Mutters, Direktor des Hygieneinstituts der Universitätsklinik Bonn. Doch dass Patienten noch kranker werden, geschehe seit einigen Jahrzehnten verstärkt in Pflegeeinrichtungen und Krankenhäusern. Die Ursache: multiresistente Erreger (MRE) – im Volksmund auch „Krankenhauskeime“ genannt.
Dabei handelt es sich um Bakterien, die widerstandsfähig geworden sind. Bakterien, die man mit den herkömmlichen Antibiotika nicht mehr bekämpfen kann. Bakterien, die deutschlandweit für 2400 Todesfälle im Jahr verantwortlich sind. In den Pandemiejahren sei die Gefahr, die von den multiresistenten Erregern ausgehe, aus dem Fokus gerückt, sagt Mutters.
Corona habe MRE für eine Weile von der medizinischen Agenda verdrängt. Dabei habe es in den vergangenen 20 Jahren einen starken und stetigen Anstieg gegeben. Aktuell stünden deutschlandweit bis zu 600 Infektionen im Zusammenhang mit einer medizinischen Behandlung. Ein Drittel davon werde durch multiresistente Erreger ausgelöst. Eine sich langsam aufbauende Infektionswelle, die bisher „stiefmütterlich behandelt wurde“, so Mutters.
Alles zum Thema Corona
- Influenza, Corona und RSV Alle husten – aber die Grippe-Welle kommt erst noch
- Gottesdienst-Stream Diese Gemeinden laden im Kreis Euskirchen zum virtuellen Kirchgang ein
- Punk in Köln Teil III „Ich bin straight edge und alles, was Köln ausmacht, ist Karneval und saufen“
- Stratus-Variante am häufigsten Mehr Corona-Infektionen in NRW – Die Zahlen in Köln und der Region
- Erkältungssaison Bislang nur vereinzelte Fälle von Corona-Infektionen in Rhein-Erft
- Corona-Pandemie Enquete-Kommission startet Aufarbeitung – Neue dominante Variante
- Trumps Minister Wie Robert F. Kennedy die amerikanische Gesundheitsbehörde säubert
Kreis Euskirchen in Netzwerk von 80 Kliniken
Um gegen diese Problematik vorzugehen, ist der Kreis Euskirchen nun – nach dem Beitritt in das Infektionsschutznetzwerk „euPrevent“ – auch dem Netzwerk „mre-netz regio rhein-ahr“ beigetreten. Das Netzwerk ist ein Zusammenschluss von zehn Kreisen, mehr als 200 Pflegeeinrichtungen und 80 Kliniken – in enger Zusammenarbeit mit dem Institut für Hygiene und öffentliche Gesundheit des Universitätsklinikums in Bonn.
Das Credo: Nur gemeinsam können Krankenhäuser und Pflegeeinrichtungen Fortschritte in der Bekämpfung multiresistenter Erreger machen. Aus Corona lernen „Die Coronapandemie hat verdeutlicht, mit welcher rasanten Geschwindigkeit sich Infektionskrankheiten weltweit verbreiten können“, sagte Christian Ramolla, der Leiter des Kreisgesundheitsamts. Mutters sagt, dass manche Krankheitswellen laut und schnell seien. Sich im Vordergrund abspielen. Wie Corona. Andere hingegen seien leise und schleichend. Wie MRE-Infektionen. Das mache sie nicht weniger gefährlich.
Corona-Pandemie hat Bedeutung von Kooperation verdeutlicht
Im Gegenteil: Im Hintergrund entwickelten sie sich stetig weiter, bis man ihrer nicht mehr Herr werde. Für diese „leisen Pandemien“ könne man aber von der lauten, von der schnellen Pandemie lernen – von dem, was gut gelaufen ist, und auch von dem, was weniger gut gelaufen ist. Die Coronapandemie habe deutlich gemacht, wie wichtig Zusammenarbeit, Kooperation und Vernetzung im Bereich des Gesundheitsschutzes ist.
Wie wichtig der fachliche Austausch zwischen den einzelnen Kliniken und Gesundheitsämtern. Auch, dass es an dieser Stelle Nachholbedarf gebe, habe die Pandemie gezeigt. Zu diesem Schluss kommt Landrat Markus Ramers. Fehlende Strukturen Genau darum geht es bei dem Netzwerk auch: Austausch zwischen Kliniken, Pflegeeinrichtungen und Gesundheitsämtern, sagt Christian Ramolla. „Wir haben einfach keine Struktur, um im Zusammenhang mit Infektionsfällen jemand anrufen und um Hilfe bitten zu können.“
Die Feuerwehr oder die Polizei in Euskirchen hätten bei Hilfeersuchen immer die Möglichkeit, in Düren oder in Erftstadt anzurufen. „Wir haben diese Möglichkeiten nicht“, sagt Ramolla. Deswegen biete das Netzwerk fortan überörtliche Hilfe und Unterstützung bei infektionsmedizinischen Notlagen und Unsicherheiten an. Die Bekämpfung der MRE-Infektionen war nämlich von Anfang an von Unsicherheiten und Überforderungen geprägt. „Wir haben rumgeeiert“, sagt Ramolla.
Er erinnert sich an die ersten MRE-Ausbrüche in den Pflegeeinrichtungen des Kreises: „Wir haben damals überlegt, ob man die infizierten Menschen einfach wegschließen kann.“ Auch ein Amtsrichter sei damals dabei gewesen. Auf der einen Seite habe man natürlich verhindern wollen, dass die Patienten über die Stationen und durch die Pflegeeinrichtungen laufen und die Erreger sich ausbreiten. Auf der anderen Seite habe man versucht, einen sozialen Umgang mit MRE-Patienten zu finden.
Von dem Beitritt in das Netzwerk erwartet Ramolla eine geregelte Kommunikation, klare Handlungsabläufe und überregionale Unterstützung. „Denn wir haben durch Corona auch vor Augen geführt bekommen, dass Insellösungen nicht funktionieren“, sagt Ramolla. Man könne in den Kreis-Institutionen eben nicht durch Literatur- oder Internetrecherche selbst herausfinden, welche neuen Keime es gebe. Das sei auch nicht nötig, findet Niko Mutters. Und dass nicht jede Einzel-Einrichtung das Rad neu erfinden müsse, sagt er.
Multiresistente Keime verbreiten sich rasend schnell
Der Vorteil eines Netzwerkes sei doch, dass an dieser Stelle eben einer für alle arbeite. Dass keine Ressourcen verschwendet würden und keine Zeit verloren gehe. Die Verbreitung neuer multiresistenter Keime laufe in den Kreisgebieten nämlich rasend schnell ab, weiß Niko Mutters. „Es gibt viel Bewegung und keine festen Grenzen mehr. Es gibt viel Pendelverkehr – bei Bewohnern genauso wie bei Patienten.“
Wer in Euskirchen wohne, könne trotzdem in ein Krankenhaus nach Düren, Köln oder Aachen verlegt werden – und andersherum. Es gebe viel Fluktuation. Das beinhalte auch unterschiedliche Hygieneleistungen. Und Kommunikationsschwierigkeiten, bis hin zum Kommunikationsverlust: „Da wird dann ein Patient verlegt, und das aufnehmende Krankenhaus weiß gar nicht, dass der Patient einen multiresistenten Erreger in sich trägt.“ So trage man die Keime weiter, von Krankenhaus zu Krankenhaus.
Durch die Vernetzung der Welt kommen die widerstandsfähigen Keime aber nicht nur aus Düren oder Köln, sondern auch aus Indien in den Kreis. Ein Netzwerk habe dann den Vorteil des schnellen Austauschs. Welche Keime gibt es? Was haben andere Krankenhäuser und Pflegeeinrichtungen aktuell für Probleme? Wie handhaben sie diese?
Wichtiger Baustein ist der überlegte Einsatz von Antibiotika
Maßnahmen, die das Netzwerk ergreifen will, sind zum einen eine verbesserte Hygiene. Standardisierte Hygienemaßnahmen sind in allen Netzwerk-Krankenhäusern und -Pflegeeinrichtungen vorgesehen. Nicht nur die Ausbreitung bestehender, sondern auch das Entstehen neuer resistenter Keime könnten so verhindert werden. Auf der anderen Seite stehe das Prinzip „Antibiotic Stewardship“ – ein rationaler und verantwortungsvoller Einsatz von Antibiotika. Die Ärzte gäben viele Antibiotika willkürlich, sagt Mutters. Zum Beispiel, wenn jemand Schnupfen habe. Mutters: „Und das, obwohl Schnupfen in 99 Prozent der Fälle ein Virus ist, bei dem Antibiotika gar nicht wirken.“
Es brauche also Fachpersonal. Jemanden, der sich auskennt. Jemanden, der sagt, wann ein Antibiotikum gegeben werden kann und wann nicht. Denn durch die übermäßige Vergabe und einen gedankenlosen Antibiotikaeinsatz entwickelten sich die Resistenzen.
Corona-Pandemie hat Bedeutung von Gesundheitsschutz gezeigt
Durch die Coronapandemie ist das Team Gesundheitsschutz des Kreises stark angewachsen. Gemeinsam werden in „normalen“ Jahren kreisweit rund 1000 bis 1200 Infektionsfälle betreut. Corona hat dies in 2022 allerdings auf knapp 80.000 Fälle anwachsen lassen. Zusätzlich werden im Kreis rund 900 Einrichtungen kommunalhygienisch überwacht.
Dazu zählen neben Krankenhäusern, Pflegeeinrichtungen und Wasserwerken unter anderem auch Tattoostudios und Gemeinschaftsunterkünfte für Flüchtlinge. Ein Förderprogramm der Bundesregierung ermöglichte außerdem die Einrichtung einer Stelle zur Planung von infektionsmedizinischen Notfalllagen und der Fachstelle Umweltmedizin. (kkr)

